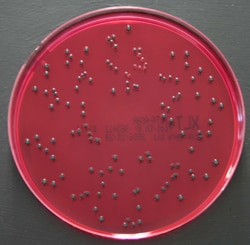
Thermo Scientific Gélose X.L.T.4 | Buy Online | Thermo Scientific&trade; | Fisher Scientific

Learn More
Thermo Scientific™ Gélose X.L.T.4
Description
Isolez les salmonelles dans les échantillons cliniques, environnementaux et alimentaires grâce au milieu Thermo Scientific™ Oxoid™ X.L.T.41. La présence de Tergitol 4 (également connu sous le nom de Niaproof 4), un surfactant anionique, crée un milieu hautement sélectif inhibant la flore de fond. Cette sélectivité améliorée permet une augmentation significative de la récupération des salmonelles, tout en réduisant les faux positifs. Il a été prouvé que le milieu X.L.T.4 permet de gagner du temps et des coûts associés à l’identification des colonies à faux positifs par rapport à d’autres milieux d’étalement de salmonelles.2
Utilisez le milieu X.L.T.4 pour isoler les espèces de Salmonella dans des échantillons cliniques, environnementaux et alimentaires.
- Facile à lire : les salmonelles apparaissent comme des colonies noires ou rouges avec un centre noir tandis qu’Escherichia coli se développe sous forme de colonies jaunes, et que les autres organismes tels que les shigelles apparaissent comme des colonies rouges sans noircissement.
- Sélectif : la présence de Tergitol 4 inhibe la croissance de la flore indésirable, ce qui permet une augmentation significative de la récupération des salmonelles.
- Réduction des colonies suspectes faussement positives.
- Permet d’économiser du temps et de minimiser les coûts par rapport à d’autres milieux d’étalement de salmonelles.
- Facilité d’utilisation des milieux de culture prêts à l’emploi
Dans ce milieu, la différenciation est facilitée par la fermentation de la xylose, du lactose et du sucrose ainsi que par la décarboxylation de la lysine. Les salmonelles apparaissent comme des colonies noires ou des colonies rouges avec un centre noir en raison de leur capacité à réduire le thiosulfate en sulfure d’hydrogène, ce qui entraîne le noircissement de la colonie (car des ions ferriques sont présents). Les Escherichia coli prolifèrent en colonies jaunes, car elles sont capables de fermenter le lactose présent dans la formulation, ce qui entraîne une chute du pH et fait passer la couleur de l’indicateur de phénol de rouge à jaune. D’autres organismes, tels que les shigellae, ne fermentent pas le lactose et ne réduisent pas le thiosulfate, de sorte qu’ils apparaissent comme des colonies rouges transparentes sans noircissement.
Les produits ne sont pas tous disponibles à la vente dans tous les pays. Veuillez nous contacter.
Les produits Remel™ et Oxoid™ font désormais partie intégrante de la marque Thermo Scientific

Spécification
Spécification
| Contenu et stockage | 2°C à 10°C |
| Format | Plaque |
| Origine de la fabrication | Allemagne |
| Type de produit | Gélose |
| Quantité | 10 |
Veuillez fournir vos retours sur le contenu du produit en remplissant le formulaire ci-dessous.